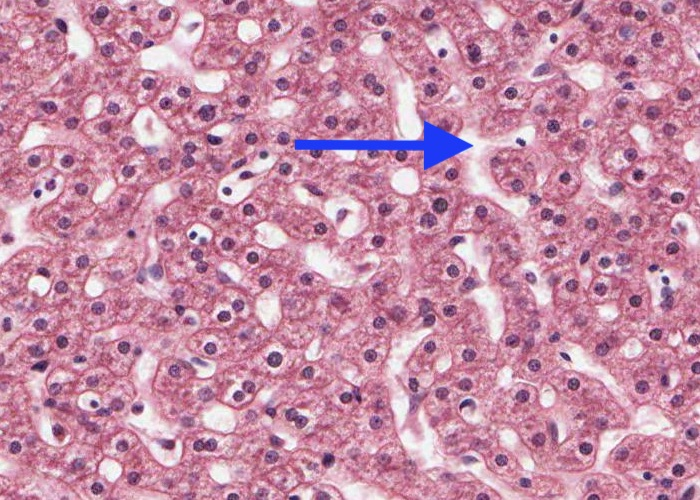
<p>The structure (x20) whose lumen is arrowed is a?</p>

1/35
Looks like no tags are added yet.
Name | Mastery | Learn | Test | Matching | Spaced | Call with Kai |
|---|
No analytics yet
Send a link to your students to track their progress

What organ is this?

The liver is the largest gland in the body.
CT (collagen) is stained green in this section
Very little CT - except for a trabeculum which surround each major blood vessel and physically supports organ.
A fibrous (collagenous) connective tissue layer (Glisson’s capsule) surrounds the liver.


central vein running by itself among the hepatocytes.
It has little more than a sheet of endothelium (squamous endothelial cells) for its wall, with a minimum of connective tissue (collagen; stained green).


Find a portal area ( = portal triad) of connective tissue and identify the structures in it; branches of the portal vein, hepatic artery and bile duct (cuboidal epithelium). Some of these may be duplicated because they are continually branching - and they also may be of different sizes.


Observe the liver parenchyma. It is composed of irregular networks of hepatocytes which look like "cords" of cells. The real arrangement in three dimensions is that of anastomosing sheets of cells. Between each sheet of hepatocytes is a blood sinusoid.


Hepatocytes are large cells (15-35 micrometres in diameter).
The nucleus is located in the centre of the cell – many are binucleate cells (two nuclei).
Cuboidal shaped and therefore with six surfaces – two (basal) surfaces abut the sinusoids; the remaining (lateral and apical) surfaces are adjacent to other hepatocytes and a bile canaliculus.


One important role of the liver is carbohydrate metabolism. The liver phosphorylates glucose that it absorbs from the GI tract to glucose-6-phosphate and then this is used in the glycolytic pathways or stored as glycogen. The special PAS stain shows the glycogen staining pink here in the cytoplasm of hepatocytes.


The liver is also an exocrine gland with bile as its exocrine secretion.
Every hepatic cell is in contact with at least one bile canaliculus, which it secretes bile into.
These canaliculi form an anatomizing network which eventually drains into a bile duct in the portal area.
The canaliculi actually are very narrow channels between every two adjacent hepatocytes and do not have any other wall of their own.
If you look closely at maximum magnification you may be able to see them running between adjacent hepatocytes.
Longitudinally, bile canaliculi look like a double line running between cells.
In cross section you see them as a tiny donut in the middle of the boundary between cells.


This section demonstrates the capacity of Kupffer cells for phagocytosis.
At this magnification you can see blue dots scattered around the field.
Particles of trypan blue were injected intravenously into this animal and the macrophages gorged themselves.
These macrophages help form the sinusoidal lining.
This section of liver is only six micrometres/microns thick, so there must be a lot of these cells in the whole liver.
The nucleus of each hepatocyte is nicely visible but the occasional red blotches are staining artifact. Do not worry about them.


In the last item a Kupffer cell (which is also called a "stellate sinusoidal macrophage") was described as helping form the sinusoidal lining. Another specialized cell that is also associated with the endothelial cells and a sinusoid is the "Ito cell" - or hepatic stellate cell. "Stellate" means "star-shaped". These Ito cells store vitamin A. You may find out more about these cells if you study pathological conditions of the liver.
So look at a sinusoid in this image. The Kupffer cell (macrophage) is usually identified by having a oval shaped nucleus and often you may see the cytoplasm of one of these cells protruding into the sinudoid lumen. Remember an endothelial cell would have a squamous (flat) nucleus. The Ito cell would be expected to be a very pale cell containing perhaps lipid droplets but don't expect to be able to discern one in this image. Just appreciate they can be located as part of the sinusoidal lining.


Observe again the parenchyma and the hepatocytes.
The real arrangement in three dimensions is that of anastomosing sheets of cells.
Between these sheets are blood sinusoids.
Note the flattened nucleus of each cell lining them.
They belong to an endothelial cell and those with perhaps a more oval nucleus would be a Kupffer cell (macrophage).


Very important metabolic exchanges occur directly between the hepatocytes and the blood.
Hepatocytes secrete many compounds from glucose to serum proteins into the blood.
To facilitate this endocrine secretion the expected basement membrane of both the endothelial cells and the hepatocytes is absent.
Without this glue, a narrow perisinusoidal space (of Disse) develops between the two epithelia.
In this section, shrinkage artifacts exaggerate the width of this space of Disse, allowing you to see it more easily.
The darker border between hepatocytes would represent the longitudinally oriented bile canaliculus.


This preparation clearly shows the relationship of the gall bladder to the liver.
If you view the H&E histological section of the gallbladder from the link below raise the magnification until you can identify the major block of tissue to be liver.
The gallbladder is attached like a bag to the underside of the liver.
Thus, one side of the gall bladder is covered with a serosa, the other with an adventitia.


Find the irregular folding of the surface of the gallbladder, noting that its folds are not villi.
Note the epithelium, simple lamina propria, and subjacent smooth muscle (muscularis externa).
The wall of the gallbladder lacks a muscularis mucosa and submucosa.
The main functions of the gallbladder are to concentrate and to store bile produced by the liver cells.
The concentrate is released in response to the digestive hormone, cholecystokinin.


The tall columnar cells have microvilli and ultrastructural features typical of an absorptive cell. During active fluid movement from the lumen across to the blood vessels in the underlying connective tissue (lamina propria) a swollen intercellular space is visible with the light microscope.


There are two sections of the pancreas for you to view (see below). However, view them to see different histological features that are emphasised in each section. The H&E section best illustrates the serous acini. The Trichrome stained section is a little too overstained and so the serous acini are not well presented - but the ducts are very nicely stained and easy to see. In this module some items are repeated, showing images from the different stained sections.
Begin at low magnification by noting that the pancreatic parenchyma has a bright pink/redish color and the connective tissue is seen as predominantly pale lines. Be aware that some purple stained areas are lymphatic tissue. The fairly well defined lobules of the pancreas are separated by interlobular septa of connective tissue.


The pancreas has endocrine as well as exocrine functions.
Within a lobule such as you can see imaged here the exocrine portion of the gland is a compound acinar gland with ducts.
It makes up the darker staining bulk of the lobule.
A fairly large intralobular duct is visible with homogenous pink stained contents in the lumen and it is surrounded but connective tissue.
The clear space may be a portion of connective tissue which was filled with fat cells (adipocytes) or perhaps a large venule or even a lymphatic channel.
The endocrine portion is the series of islets of Langerhans ( = pancreatic islets) that you can see as rounded paler areas embedded within the lobules. You examined these pancreatic islets when you studied the "Endocrine system".


Look at a lobule at high magnification. It is filled with irregularly shaped acini each showing 2 to 10 nuclei in each. Each nucleus is located at the basal end of the cell, which is distinctly basophilic. This is where the rough/granular endoplasmic reticulum (gER) of the cell is located. The upper half of the cell is packed with eosinophilic secretory granules. These contain zymogens (inactive precursors to digestive enzymes). The pancreas makes a variety of digestive enzymes for the duodenum and each acinar cell synthesizes the full range of them.


One histological feature worth pointing out (but will be revisisted with the Trichrome stained image) is the centroacinar cell.
The acinus has an interesting specialization, centroacinar cells. Where a terminal intercalated duct meets an acinus it protrudes into it so that some duct cells lie right in the middle of the acinus. This is one reason that the acini are irregular in shape. The centroacinar cells appear as an extra nucleus or two in the middle of those acini which have been sectioned through their centre. They and the other intercalated duct cells secrete an alkaline fluid, under command of the hormone secretin, to help neutralize the pH of the material passing into the duodenum from the stomach.
In this image the nucleus of the centroacinar cell appears ovoid but this is because the view is as if you are looking down on the flattened cell. They are in fact a squamous cell with a flattened nucleus. In the trichome stained section you will see this more obviously.
Don't bother searching for an intercalated duct in this section. They are so hard to see and distinguish from small blood capillaries as this section does show the immense vascularity of the pancreas. You will see them clearly in the trichrome stained section.


Within a lobule of this trichrome stained section again the darker staining bulk of the lobule are serous acini but too overstained to see much detail. A fairly large islet of Langerhan ( = pancreatic islet) is the rounded, paler area embedded within the lobule. Again, you examined the pancreatic islet when you studied the "Endocrine system".


The beginning of the duct system in the pancreatic exocrine component begins with the centroacinar cell. They are a squamous cell with a flattened nucleus. They are actually a continuation of the short, intercalated duct which are located just outside each acinus.


Intercalated ducts (lined by a simple squamous epithelium) are very short and pass their secretion products into an intralobular duct (which is not striated a duct) characterized initially by having a low cuboidal epithelium.


Like the parotid gland the pancreas is an all serous acinar gland. Look for intralobular ducts between the serous acini as a small duct lined with low columnar or cuboidal epithelium. The one clearly visible in this image has been sectioned longitudinally and also transversely. The ducts vary substantially in size, being very small as they leave the individual acini and growing as they progressively fuse and also become surrounded by increasing amounts of connective tissue. Eventually they drain into interlobular ducts which leaves the lobule and then pass their secretion contents into an excretory duct.


So with this stain you can more clearly see the connective tissue surrounding the intralobular duct. Intercalated ducts will pass their secretion products into this intralobular duct (which are not striated duct). Note this one has a lining of cuboidal epithelium but as these ducts increase in size the epithelium will change to low columnar then simple columnar.


The interlobular duct leaves the lobule and is surrounded by a rather thick layer of connective tissue. The lining cells can be cuboidal or low columnar. In the H&E section there are not many good examples of an interlobular duct but you will see them more obviously in the trichrome-stained section.


This interlobular duct is on the edge of a lobule and already shows signs of the epithelium transitioning to a simple columnar epithelium although parts will still exhibit a simple cuboidal epithelium.
A good exercise is to make sure you don't confuse sections through the pancreatic duct system with sections of blood vessels of various sizes.


While scanning this section you may see a large interlobular duct lined with simple columnar epithelium and heavily invested with connective tissue. Large blood vessels are also present.

The circular structure who clumen is arrowed is a?
Bile duct

In this image of the pancreas, what is arrowed and what is circled?
the endocrine pancreas is circled and the exocrine component is arrowed.

The structure circled is a?
portal triad

The very thin pink line (tissue) arrowed (1.25x) is the?
Muscularis externa
The structure (x20) whose lumen is arrowed is a?
hepatic/liver sinusoid

The circular structure (x10) whose lumen is arrowed is a?
hepatic artery

The circular structure whos elumen is arrowed (x10) is a?
central vein

The clear space (arrowed; X20) between the cells lining the gallbladder hint at the functional role of the gallbladder i.e.
to concentrate and to store bile produced by the liver cells. The concentrate is released in response to the digestive hormone, cholecystokinin.

The circular structure (X10) whose lumen is arrowed is a
portal vein